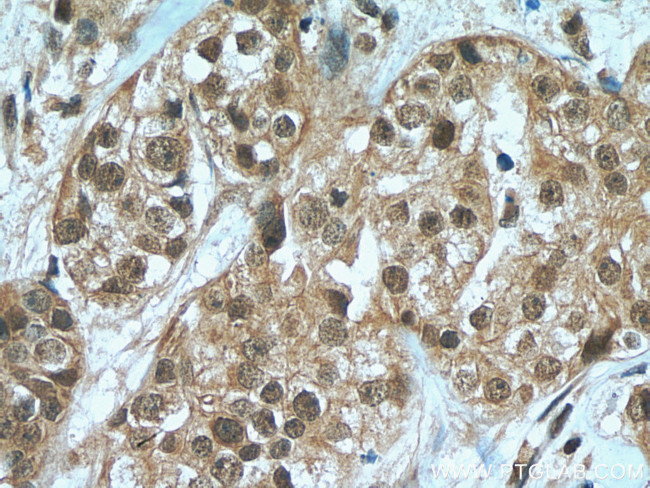
HORMAD1 Antibody in Immunohistochemistry (Paraffin) (IHC (P))

Search
Proteintech
HORMAD1 Polyclonal Antibody
{{$productOrderCtrl.translations['antibody.pdp.commerceCard.promotion.promotions']}}
{{$productOrderCtrl.translations['antibody.pdp.commerceCard.promotion.viewpromo']}}
{{$productOrderCtrl.translations['antibody.pdp.commerceCard.promotion.promocode']}}: {{promo.promoCode}} {{promo.promoTitle}} {{promo.promoDescription}}. {{$productOrderCtrl.translations['antibody.pdp.commerceCard.promotion.learnmore']}}
产品信息
28719-1-AP
种属反应
宿主/亚型
分类
类型
抗原
偶联物
形式
浓度
规格
纯化类型
保存液
内含物
保存条件
运输条件
产品详细信息
Aliquoting is unnecessary for -20°C storage.
靶标信息
This gene encodes a HORMA domain-containing protein. HORMA domains are involved in chromatin binding and play a role in cell cycle regulation. The encoded protein may play a role in meiosis, and expression of this gene is a potential marker for cancer. A pseudogene of this gene is located on the long arm of chromosome 6. Alternatively spliced transcript variants encoding multiple isoforms have been observed for this gene.
仅用于科研。不用于诊断过程。未经明确授权不得转售。
生物信息学
蛋白别名: Cancer/testis antigen 46; CT46; DKFZP434A1315; HORM1; HORMA domain containing protein; HORMA domain-containing protein 1; Newborn ovary HORMA protein; testis tissue sperm-binding protein Li 86P; unnamed protein product
基因别名: 4921522K05Rik; CT46; HORMAD1; NOHMA; RGD1564960
UniProt ID: (Human) Q86X24, (Mouse) Q9D5T7, (Rat) D3ZWE7
Entrez Gene ID: (Human) 84072, (Mouse) 67981, (Rat) 365868